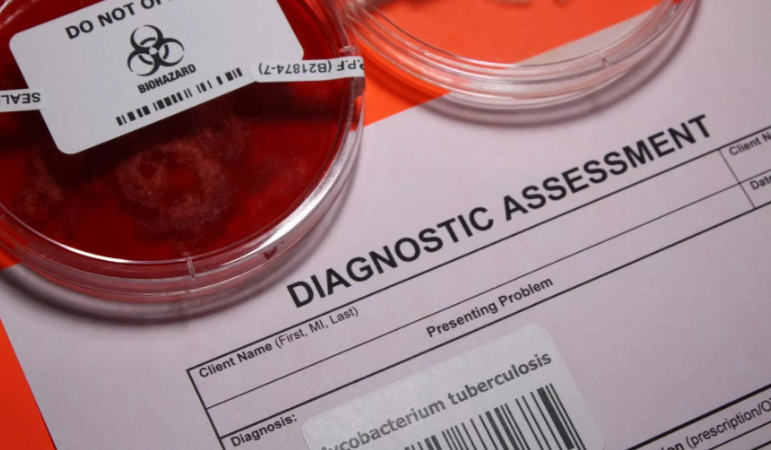

Europa do të humbasë objektivat e saj për të luftuar HIV-in, tuberkulozin (TB), hepatitin dhe infeksionet seksualisht të transmetueshme (SST) pa investime të rëndësishme në shëndetin publik, kanë paralajmëruar autoritetet shëndetësore.
Këto sëmundje shkaktojnë afro 57,000 vdekje çdo vit në Bashkimin Evropian, Islandë, Lihtenshtajn dhe Norvegji, sipas raportit të ri nga Qendra Evropiane për Parandalimin dhe Kontrollin e Sëmundjeve (ECDC).
Por shumë vende nuk janë në rrugën e duhur për të përmbushur qëllimet zyrtare për të eliminuar epidemitë e sëmundjeve infektive deri në vitin 2030, dhe rajoni nuk i ka përmbushur shumicën e këtyre objektivave për vitin 2025.
“Këto sëmundje janë të parandalueshme, ashtu siç është barra që vendet vendosin mbi sistemet shëndetësore, pacientët dhe familjet e tyre”, thotë drejtoresha e ECDC Pamela Rendi-Ëagner.
Është bërë njëfarë progresi. Numri i infeksioneve të reja me HIV ka rënë me 35 për qind që nga viti 2010 dhe incidenca e TB është ulur me 35 për qind që nga viti 2015, megjithëse objektivat e rajonit ishin një reduktim përkatësisht 75 për qind dhe 50 për qind deri në vitin 2025.
SST-të arrijnë nivele rekord
Numri i vdekjeve nga shkaqe të lidhura me SIDA-n ka rënë me 30 për qind që nga viti 2010, me 3300 vdekje në vitin 2023. Por zyrtarët shëndetësorë thonë se ky numër duhet të përgjysmohet.
Vdekjet nga hepatiti B dhe C mbeten të larta dhe rastet e hepatitit akut B janë në rritje. Infeksionet përhapen përmes kontaktit seksual ose kur përdoruesit e drogës ndajnë shiringa të kontaminuara dhe mund të shkaktojnë cirrozë dhe kancer të mëlçisë.
Ndërkohë, përqindjet e SST-ve si sifilizi dhe gonorreja po arrijnë nivele rekord.
Autoritetet tani zbulojnë pothuajse të gjitha rastet e reja dhe të përsëritura të tuberkulozit, por rezistenca dhe trajtimi ndaj ilaçeve mbeten sfiduese. Në vitin 2022, vetëm 68 për qind e njerëzve që filluan trajtimin e tuberkulozit në fakt e përfunduan atë, duke mos arritur objektivin 90 për qind të rajonit.
ECDC bën thirrje për përpjekje shtesë për parandalimin e këtyre sëmundjeve, për shembull përmirësimin e marrjes së profilaksisë para ekspozimit (PrEP) për të ndihmuar në parandalimin e infeksionit HIV, rritjen e vaksinimeve për hepatitin B dhe ndërgjegjësimin për të përdorur masa mbrojtëse gjatë marrëdhënies.
Agjencia gjithashtu dëshiron që vendet të zgjerojnë shërbimet e testimit në përpjekje për të zbuluar infeksionet më herët, për të mbështetur mbledhjen e të dhënave dhe për të ndërmarrë hapa për të ndihmuar njerëzit me sëmundje si TB, për të cilat ata duhet të marrin pilula ditore për katër deri në nëntë muaj, të qëndrojnë në trajtimin e tyre.
Copyright © Gazeta “Si”
Të gjitha të drejtat e këtij materiali janë pronë ekskluzive dhe e patjetërsueshme e Gazetës “Si”, sipas Ligjit Nr.35/2016 “Për të drejtat e autorit dhe të drejtat e tjera të lidhura me to”. Ndalohet kategorikisht kopjimi, publikimi, shpërndarja, tjetërsimi etj, pa autorizimin e Gazetës “Si”, në të kundërt çdo shkelës do mbajë përgjegjësi sipas nenit 179 të Ligjit 35/2016.
.png)